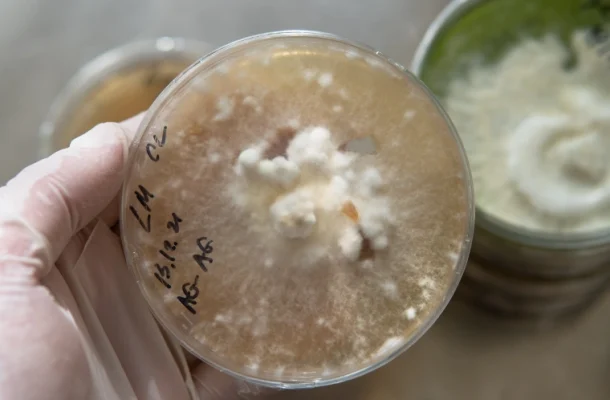

Gastroenteritis
- Understanding Gastroenteritis: Key Facts You Need to Know
- Stay Informed: Essential Facts About Gastroenteritis
- Know the Facts: Protect Yourself from Gastroenteritis
- Gastroenteritis Uncovered: Important Information for Your Health

Gastroenteritis
- Understanding Gastroenteritis: Key Facts You Need to Know
- Stay Informed: Essential Facts About Gastroenteritis
- Know the Facts: Protect Yourself from Gastroenteritis
- Gastroenteritis Uncovered: Important Information for Your Health

Quick Relief and Expert Care At NextGen Walk-in Clinic & Urgent Care
We provide fast, professional treatment for gastroenteritis, helping you recover as quickly as possible with expert advice and effective solutions.
Comprehensive Diagnostics and Treatment
From determining the cause of your gastroenteritis to recommending personalized treatment plans, we ensure thorough care tailored to your symptoms and needs.
Convenient, No-Appointment Needed Care
Sick with gastroenteritis? Don’t wait for an appointment—visit us anytime! Our walk-in clinic ensures you get the care you need without the long wait.
Compassionate and Supportive Staff
Dealing with gastroenteritis can be tough, but our caring team is here to provide reassurance, offer guidance, and support you throughout your recovery journey.

Gastroenteritis: Symptoms, Treatment, and How NextGen Can Help
Gastroenteritis, commonly known as the “stomach flu,” is an inflammation of the stomach and intestines caused by infections from viruses, bacteria, or parasites. It is a common condition that affects people of all ages and often leads to symptoms such as vomiting, diarrhea, abdominal cramps, and fever. Although often referred to as the “stomach flu,” gastroenteritis is not related to the influenza virus, which primarily affects the respiratory system.
Important Facts You Should Know About Gastroenteritis
Though it shares some symptoms with the flu, gastroenteritis is not caused by the influenza virus but by infections from viruses, bacteria, or parasites.
• Viruses: Norovirus, rotavirus, adenovirus.
• Bacteria: Salmonella, E. coli, Campylobacter.
• Parasites: Giardia, Entamoeba histolytica.
Gastroenteritis is highly contagious and can spread easily through food, water, and contact with infected individuals or surfaces.
Gastroenteritis causes digestive distress, with symptoms varying in severity. Diarrhea and vomiting are the most common signs.
Because gastroenteritis causes fluid loss through diarrhea and vomiting, staying hydrated is vital. Oral rehydration solutions can help restore electrolytes and fluids.
After exposure, symptoms can develop within a few hours to a few days, depending on the cause of the infection.
In many cases, gastroenteritis resolves on its own within a few days with proper rest, hydration, and self-care.
While common in children and older adults, people of all ages can get gastroenteritis. The severity often depends on the individual’s immune system and overall health.
People with gastroenteritis can be contagious from the moment they start feeling ill and for several days after symptoms subside.
Gastroenteritis outbreaks are often linked to contaminated food, particularly undercooked meats, seafood, unwashed vegetables, and contaminated water sources.
In severe cases, particularly in young children, elderly adults, or those with weakened immune systems, dehydration can become a serious complication and may require medical intervention.
Regular handwashing, especially before eating or preparing food, and ensuring food is cooked thoroughly are key steps in preventing gastroenteritis.
Since many cases of gastroenteritis are viral, antibiotics are not effective. Treatment generally focuses on managing symptoms rather than treating the infection directly.
A vaccine for rotavirus, one of the most common viral causes of gastroenteritis in children, is available and recommended in many countries.
A vaccine for rotavirus, one of the most common viral causes of gastroenteritis in children, is available and recommended in many countries.
Why Choose NextGen Walk-in Clinic & Urgent Care for Gastroenteritis Treatment?
When you’re dealing with the discomfort and inconvenience of gastroenteritis, you want quick, reliable care to help you recover. NextGen Walk-in Clinic & Urgent Care is your trusted partner for managing gastroenteritis symptoms and ensuring you get the best treatment possible. Here’s why choosing us for your care makes sense:
At NextGen Walk-in Clinic & Urgent Care, we understand that when you’re feeling sick, the last thing you want is to wait for an appointment. With no appointment needed, you can walk in and get the treatment you need quickly, so you don’t have to suffer through long waiting times or hospital visits.
Our medical professionals are trained to identify and treat gastroenteritis caused by viruses, bacteria, or parasites. We provide accurate diagnoses and effective treatments to help you feel better fast. Whether you need medication for symptoms, hydration therapy for dehydration, or just advice on managing your condition, we’ve got you covered.
We know that each patient is unique, and gastroenteritis can affect people in different ways. That’s why we offer personalized care tailored to your specific symptoms. Our team will take the time to understand your condition and provide recommendations, whether it’s dietary adjustments, over-the-counter medications, or referrals for further treatment if needed.
Dealing with gastroenteritis can be exhausting, and the last thing you need is to feel like just another patient. At NextGen Walk-in Clinic & Urgent Care, we prioritize compassion in every interaction. Our friendly staff is here to support you through the entire process, answering questions, offering reassurance, and making sure you’re comfortable throughout your visit.
In some cases, gastroenteritis symptoms may persist or lead to complications, like dehydration. If necessary, we offer follow-up support to ensure that you’re on the road to recovery. We also provide guidance on preventing future infections and managing your digestive health long-term.


Common Causes of Gastroenteritis
The main causes of gastroenteritis are infections by various pathogens, including viruses, bacteria, and parasites. Each type of infection can lead to different symptoms and severity, but the result is usually similar—a disturbance in the digestive system that causes discomfort and digestive upset.
• Norovirus: This is the most common cause of viral gastroenteritis. Norovirus outbreaks are often associated with places like cruise ships, restaurants, and nursing homes.
• Rotavirus: Common in young children, rotavirus can cause severe diarrhea and vomiting. It is a leading cause of childhood gastroenteritis worldwide.
• Adenovirus: This virus can also lead to gastroenteritis, particularly in young children. Symptoms typically include vomiting, diarrhea, and fever.
• Salmonella: Often contracted through contaminated poultry or eggs, Salmonella infection can cause fever, diarrhea, and abdominal cramps.
• E. coli: Certain strains of E. coli, particularly those found in undercooked beef or contaminated produce, can lead to severe gastrointestinal illness, including bloody diarrhea.
• Campylobacter: Often linked to raw or undercooked poultry, Campylobacter infection can cause symptoms similar to those of Salmonella.
• Giardia: A common cause of gastroenteritis in developing countries, Giardia is a parasite that spreads through contaminated water sources, leading to symptoms like diarrhea and bloating.
• Entamoeba histolytica: This parasite is responsible for amoebic dysentery and can cause severe abdominal pain, diarrhea, and fever, often after consuming contaminated food or water.
Contaminated Food or Water: The Main Sources of Infection
Gastroenteritis is often spread through contaminated food and water, making it a highly contagious disease. Poor food handling, such as improper storage or failure to wash hands properly, can lead to bacterial or viral contamination. Drinking contaminated water, especially in areas with poor sanitation, is another common route of infection. Foodborne outbreaks of gastroenteritis are particularly common in areas with inadequate food safety practices, but they can also occur in restaurants and homes where food is not prepared or cooked properly.

How Gastroenteritis Spreads
Gastroenteritis is highly contagious and can spread easily through multiple channels:
- Contaminated Food and Water: As mentioned, infected food or water is one of the most common ways gastroenteritis is transmitted. If someone eats or drinks something contaminated with bacteria, viruses, or parasites, they are at risk for developing the infection.
- Contact with Infected Surfaces: The virus or bacteria can survive on surfaces for hours or even days, making it easy for the infection to spread through contact with contaminated surfaces, such as doorknobs, countertops, or utensils.
- Close Contact with Infected Individuals: The infection can also spread through close contact with someone who is already sick, such as touching or shaking hands, hugging, or even sharing food or drinks.
Symptoms of Gastroenteritis
Gastroenteritis, commonly referred to as the “stomach flu,” is an infection that causes inflammation in the stomach and intestines. This condition is known for its distressing symptoms, which can range from mild to severe. If you are experiencing any of the following symptoms, it could be a sign of gastroenteritis:
One of the primary symptoms of gastroenteritis is diarrhea, which typically presents as loose or watery stools. This may occur several times a day and can sometimes be accompanied by urgency or the need to rush to the bathroom.
Often appearing suddenly, nausea and vomiting are frequent symptoms of gastroenteritis. This can lead to dehydration, especially if vomiting is persistent or severe, and may require prompt attention to maintain hydration levels.
Gastroenteritis causes inflammation and irritation in the gastrointestinal tract, leading to abdominal discomfort, cramps, and sometimes bloating. The pain can vary in severity, from mild discomfort to sharp cramps.
A low-grade fever is common with gastroenteritis, particularly if the infection is caused by bacteria. Fever is the body's natural response to infection and may help fight off harmful microorganisms.
Headaches and a feeling of extreme tiredness or fatigue are common as your body deals with the infection. Dehydration can also contribute to these symptoms, leaving you feeling weak and worn out.
Dehydration is a major concern with gastroenteritis, as diarrhea and vomiting can rapidly deplete fluids and electrolytes. Signs of dehydration include dry mouth, dark-colored urine, dizziness, lightheadedness, and general weakness. It’s important to stay hydrated to prevent complications.

Treatment for Gastroenteritis
Gastroenteritis is highly contagious and can spread easily through multiple channels:
Home Remedies
- Hydration: The most important treatment for gastroenteritis is staying hydrated. Diarrhea and vomiting can lead to rapid fluid loss, and rehydration is crucial for recovery. Drinking plenty of fluids such as water, clear broths, or electrolyte solutions (like Pedialyte) can help replace lost fluids and restore electrolyte balance.
- BRAT Diet: The BRAT diet (Bananas, Rice, Applesauce, and Toast) is often recommended because these foods are gentle on the stomach and easy to digest. They help firm up stools and provide essential nutrients without causing further irritation to the digestive system.
- Rest: Rest is crucial for your body to fight the infection and recover more quickly. Allowing your immune system time to do its job can help you recover faster and feel better sooner.
Over-the-Counter (OTC) Remedies
- Anti-diarrheal Medications: Over-the-counter anti-diarrheal medications, such as loperamide (Imodium), can help slow down diarrhea and reduce the number of bowel movements. However, it’s important to consult a healthcare provider before using these medications, especially in cases of bacterial infections.
- Antiemetic Medications: OTC anti-nausea medications, such as meclizine or dimenhydrinate, can help control nausea and vomiting, making it easier for you to keep fluids down and recover.
- Probiotics: Taking probiotics can help restore healthy gut flora, which may be disrupted during a gastroenteritis infection. Probiotics can aid in digestive recovery and help rebalance the microbiome.
Medical Treatment
- IV Fluids: In cases of severe dehydration, intravenous (IV) fluids may be required to quickly replenish lost fluids and electrolytes. IV hydration is especially important for individuals who are unable to keep fluids down due to persistent vomiting.
- Antibiotics: If the gastroenteritis is caused by a bacterial infection, antibiotics may be prescribed. However, antibiotics are not effective against viral infections, and overuse can contribute to antibiotic resistance. They should only be used when specifically prescribed by a healthcare provider after a proper diagnosis.
- Anti-viral or Anti-parasitic Medications: For viral gastroenteritis (such as from rotavirus or norovirus), there are no specific antiviral treatments, but supportive care is essential. In cases of parasitic gastroenteritis (such as from Giardia), anti-parasitic medications may be prescribed to target the specific pathogen causing the infection.

How NextGen Walk-in Clinic & Urgent Care Can Help
At NextGen Walk-in Clinic & Urgent Care, we are dedicated to providing fast, effective care for individuals suffering from gastroenteritis. Our clinic offers comprehensive treatment options, with a focus on getting you back on your feet as quickly as possible. Here’s how we can assist with gastroenteritis:
We provide a quick and thorough evaluation to determine the cause of your gastroenteritis symptoms, whether they are viral, bacterial, or parasitic. Early diagnosis helps guide appropriate treatment and symptom management.
For patients suffering from dehydration due to vomiting and diarrhea, we offer intravenous hydration therapy to quickly restore fluids and electrolytes. This can be a crucial step in your recovery process, especially if oral rehydration isn’t sufficient.
If needed, we can prescribe antibiotics for bacterial infections, or offer anti-nausea and anti-diarrheal medications to help control symptoms and ease discomfort.
Skip the wait times at emergency rooms—at NextGen Walk-in Clinic & Urgent Care, we offer convenient walk-in services for immediate treatment. No appointment is needed, and you’ll receive prompt, professional care when you need it most.
Our healthcare providers understand that each patient is unique, and we tailor your treatment plan to address your specific symptoms, medical history, and needs. Whether it’s dietary advice or medication recommendations, we’ll guide you through the healing process.
If your symptoms persist or if further evaluation is needed, we offer follow-up appointments and can refer you to a specialist for more in-depth care. Our goal is to ensure you fully recover and stay healthy.
Gastroenteritis can be an uncomfortable condition, but with the right treatment and support, recovery is possible. If you’re experiencing symptoms, don’t wait to seek care. Visit NextGen Walk-in Clinic & Urgent Care today for expert diagnosis and effective treatment to help you feel better quickly!
Prevention Tips for Gastroenteritis
Gastroenteritis, while common, can be avoided or minimized with proper precautions. Here are some tips to help reduce your risk of contracting this uncomfortable illness:
One of the most effective ways to prevent gastroenteritis is to wash your hands frequently, especially after using the bathroom or handling food. Good hand hygiene helps stop the spread of the viruses, bacteria, and parasites that cause gastroenteritis. Always use soap and water, scrubbing for at least 20 seconds. When soap and water aren’t available, use hand sanitizer with at least 60% alcohol.
Gastroenteritis can be contracted from contaminated food or water. Be mindful of where and what you eat, especially when traveling. Avoid raw or undercooked foods, especially meats, seafood, and eggs. Also, steer clear of unclean water sources, including untreated tap water or water from streams and lakes that may be contaminated with pathogens.
For certain types of viral gastroenteritis, such as rotavirus, vaccines are available, particularly for young children. Vaccines can significantly reduce the risk of contracting rotavirus, a common cause of severe diarrhea and vomiting in children. Consult with your pediatrician about the rotavirus vaccine or other vaccines that may protect against gastroenteritis-causing viruses.
Proper food handling and preparation are essential in preventing bacterial gastroenteritis. Cook meats thoroughly, particularly poultry, pork, and ground beef, to kill harmful bacteria like Salmonella and E. coli. Also, refrigerate food promptly (within 2 hours) to prevent bacterial growth. Wash fruits and vegetables thoroughly before eating, and avoid cross-contamination by separating raw and cooked foods.


When to Seek Medical Help
Although gastroenteritis often resolves on its own with at-home care, there are situations where you should seek professional medical help. If you experience any of the following, it’s crucial to get evaluated by a healthcare provider:
Dehydration is one of the biggest concerns with gastroenteritis, especially if you’re vomiting or having diarrhea frequently. Signs of dehydration include dizziness, dry mouth, very little urination, and dark-colored urine. If these symptoms worsen, seek immediate medical attention to avoid complications.
A fever is common with gastroenteritis, but a temperature higher than 101°F (38.3°C) that persists for more than a couple of days can be a sign of a more serious infection. A high fever warrants medical attention to rule out bacterial infections or complications.
The presence of blood in your stool or vomit could indicate a more severe underlying condition, such as gastrointestinal bleeding or a serious bacterial infection. This requires prompt medical evaluation to determine the cause and initiate the appropriate treatment.
If your gastroenteritis symptoms last for more than 48 hours or worsen over time, it’s essential to seek professional care. Extended or severe symptoms may indicate that the infection is not resolving on its own or that you may be dealing with a more serious health issue that requires further investigation.
Intense or persistent abdominal pain may indicate an issue beyond typical gastroenteritis. If the pain is not improving or is getting worse, it could be a sign of a more serious gastrointestinal condition that needs medical intervention.
In cases of severe dehydration, high fever, or prolonged symptoms, visit a healthcare provider or urgent care center as soon as possible to avoid complications and ensure the right course of treatment. At NextGen Walk-in Clinic & Urgent Care, we are ready to provide timely diagnosis and treatment for gastroenteritis to help you recover safely and effectively.
Customer Reviews for NextGen Walk-in Clinic & Urgent Care

Christian B.
Lorem ipsum dolor sit amet, consectetur adipiscing elit. Praesent tincidunt tortor at tempor auctor. Fusce venenatis euismod eros eget ullamcorper. Aliquam fermentum dignissim metus vel maximus. Integer quis tempor sem. Mauris placerat fermentum ornare. Nam vestibulum hendrerit purus eget auctor. Aliquam erat volutpat.

Betty C.
Lorem ipsum dolor sit amet, consectetur adipiscing elit. Praesent tincidunt tortor at tempor auctor. Fusce venenatis euismod eros eget ullamcorper. Aliquam fermentum dignissim metus vel maximus. Integer quis tempor sem. Mauris placerat fermentum ornare. Nam vestibulum hendrerit purus eget auctor. Aliquam erat volutpat.

Betty C.
Lorem ipsum dolor sit amet, consectetur adipiscing elit. Praesent tincidunt tortor at tempor auctor. Fusce venenatis euismod eros eget ullamcorper. Aliquam fermentum dignissim metus vel maximus. Integer quis tempor sem. Mauris placerat fermentum ornare. Nam vestibulum hendrerit purus eget auctor. Aliquam erat volutpat.
Frequently Asked Questions (FAQs) About Gastroenteritis
Lorem Ipsum is simply dummy text of the printing and typesetting industry. Lorem Ipsum has been the industry's standard dummy text ever since the 1500s, when an unknown printer took a galley of type and scrambled it to make a type specimen book. It has survived not only five centuries, but also the leap into electronic typesetting, remaining essentially unchanged. It was popularised in the 1960s with the release of Letraset sheets containing Lorem Ipsum passages, and more recently with desktop publishing software like Aldus PageMaker including versions of Lorem Ipsum.
Lorem Ipsum is simply dummy text of the printing and typesetting industry. Lorem Ipsum has been the industry's standard dummy text ever since the 1500s, when an unknown printer took a galley of type and scrambled it to make a type specimen book. It has survived not only five centuries, but also the leap into electronic typesetting, remaining essentially unchanged. It was popularised in the 1960s with the release of Letraset sheets containing Lorem Ipsum passages, and more recently with desktop publishing software like Aldus PageMaker including versions of Lorem Ipsum.
Lorem Ipsum is simply dummy text of the printing and typesetting industry. Lorem Ipsum has been the industry's standard dummy text ever since the 1500s, when an unknown printer took a galley of type and scrambled it to make a type specimen book. It has survived not only five centuries, but also the leap into electronic typesetting, remaining essentially unchanged. It was popularised in the 1960s with the release of Letraset sheets containing Lorem Ipsum passages, and more recently with desktop publishing software like Aldus PageMaker including versions of Lorem Ipsum.
Lorem Ipsum is simply dummy text of the printing and typesetting industry. Lorem Ipsum has been the industry's standard dummy text ever since the 1500s, when an unknown printer took a galley of type and scrambled it to make a type specimen book. It has survived not only five centuries, but also the leap into electronic typesetting, remaining essentially unchanged. It was popularised in the 1960s with the release of Letraset sheets containing Lorem Ipsum passages, and more recently with desktop publishing software like Aldus PageMaker including versions of Lorem Ipsum.
Lorem Ipsum is simply dummy text of the printing and typesetting industry. Lorem Ipsum has been the industry's standard dummy text ever since the 1500s, when an unknown printer took a galley of type and scrambled it to make a type specimen book. It has survived not only five centuries, but also the leap into electronic typesetting, remaining essentially unchanged. It was popularised in the 1960s with the release of Letraset sheets containing Lorem Ipsum passages, and more recently with desktop publishing software like Aldus PageMaker including versions of Lorem Ipsum.
Lorem Ipsum is simply dummy text of the printing and typesetting industry. Lorem Ipsum has been the industry's standard dummy text ever since the 1500s, when an unknown printer took a galley of type and scrambled it to make a type specimen book. It has survived not only five centuries, but also the leap into electronic typesetting, remaining essentially unchanged. It was popularised in the 1960s with the release of Letraset sheets containing Lorem Ipsum passages, and more recently with desktop publishing software like Aldus PageMaker including versions of Lorem Ipsum.
Lorem Ipsum is simply dummy text of the printing and typesetting industry. Lorem Ipsum has been the industry's standard dummy text ever since the 1500s, when an unknown printer took a galley of type and scrambled it to make a type specimen book. It has survived not only five centuries, but also the leap into electronic typesetting, remaining essentially unchanged. It was popularised in the 1960s with the release of Letraset sheets containing Lorem Ipsum passages, and more recently with desktop publishing software like Aldus PageMaker including versions of Lorem Ipsum.
Lorem Ipsum is simply dummy text of the printing and typesetting industry. Lorem Ipsum has been the industry's standard dummy text ever since the 1500s, when an unknown printer took a galley of type and scrambled it to make a type specimen book. It has survived not only five centuries, but also the leap into electronic typesetting, remaining essentially unchanged. It was popularised in the 1960s with the release of Letraset sheets containing Lorem Ipsum passages, and more recently with desktop publishing software like Aldus PageMaker including versions of Lorem Ipsum.
Finding Relief from Gastroenteritis at NextGen Walk-in Clinic & Urgent Care
Gastroenteritis can be both uncomfortable and disruptive to your daily life, but the good news is that most people can recover fully with the right care. While symptoms like nausea, vomiting, diarrhea, and abdominal discomfort may be distressing, timely treatment can help you feel better quickly and get back to your normal routine.
At NextGen Walk-in Clinic & Urgent Care, we understand how disruptive gastrointestinal issues can be, which is why we offer fast and effective care to address your symptoms. Whether you’re experiencing mild symptoms or more severe dehydration, we are here to provide the treatment you need. Our team is equipped to deliver hydration therapy, prescribe medications to ease your symptoms, and offer expert guidance on diet and rest during recovery.
We pride ourselves on offering walk-in services, so you don’t have to wait long for the care you need. With our personalized approach, we ensure you receive the best treatment tailored to your symptoms and recovery needs. Whether it’s a simple case of gastroenteritis or a more complex issue, NextGen Walk-in Clinic & Urgent Care is committed to helping you recover as quickly and comfortably as possible.
Don’t let gastroenteritis keep you down. Visit NextGen Walk-in Clinic & Urgent Care for the support you need to feel better and get back to your daily life. We’re here to help!